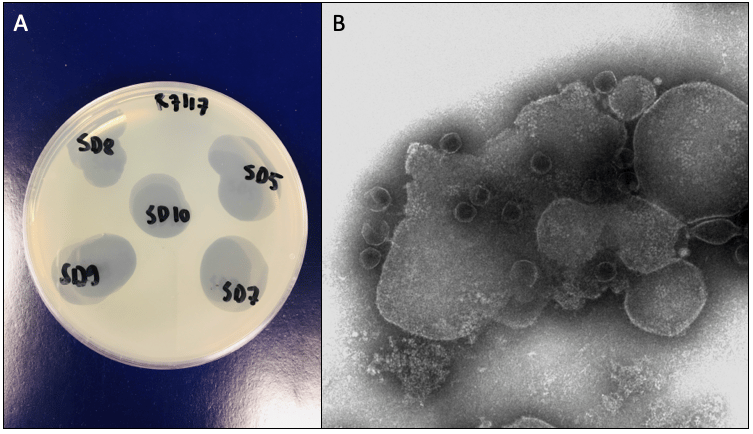

Fighting fire with fire: using pathogen-specific viruses to control plant disease outbreaks
Published in Microbiology

Explore the Research

Phage combination therapies for bacterial wilt disease in tomato - Nature Biotechnology
Phage combination therapies reduce bacterial wilt disease incidence in tomato by up to 80%.
Bacterial wilt disease caused by Ralstonia solanacearum infects several plants including tomatoes, potatoes and banana (Wei et al. 2019). It infects plants via roots rapidly spreading to aerial parts of the plant throughout the vascular system and typical wilting symptoms result from excessive production of extracellular polysaccharides that block water fluxes within the plant (Fig. 1).

Figure 1. After entering plant roots (A), R. solanacearum (B) invades the xylem vessels and rapidly spreads to aerial parts of the plant throughout the vascular system. Typical wilting symptoms result from an excessive production of extracellular polysaccharides that alter water fluxes within the plant (C). Image copyright: Ville-Petri Friman and Zhong Wei.
Here we investigated the potential of pathogen-specific viruses, phages, in controlling this notorious pathogen. Phages are often very effective at killing their host bacteria (Fig. 2) and they were used to treat bacterial infections before the invention of antibiotics. Phages are also a crucial part of natural microbiomes and often highly specific making them ideal ‘weapons’ to solely target the pathogenic bacterium leaving beneficial microbes unharmed.
Figure 2. Phage clearing zones on top of R. solanacearum bacterial lawns growing on agar plates (A). Transmission Electron Microscopy of phages infecting R. solanacearum cells (B). Image copyright: Ville-Petri Friman and Zhong Wei.
We used a combination of lab, greenhouse and field studies to test the biocontrol efficacy of phages in complex tomato rhizosphere microbiomes. Our results show that phages were very specific and did not cause collateral damage to the surrounding microbiota. However, to achieve good biocontrol efficiency, it was essential to apply phages in combinations.
Specifically, we found that phages controlled disease outbreaks via two mechanisms. First, by killing and reducing the relative abundance of the pathogen (an ecological mechanism), and second, by selecting for phage resistant but slow-growing pathogen genotypes that showed reduced competitiveness (an evolutionary mechanism). Crucially, using phages in combination magnified the effects of these both mechanisms leading to up to 80% reduction in disease incidence.
High biocontrol efficiency was also partly driven by changes in the composition of the wider microbiome: reduction in the pathogen abundance correlated with an increase in bacterial taxa that showed antagonism towards the pathogen. Phages thus triggered a downward spiral to the pathogen by selecting for reduced growth in the face of intensified competition with other bacteria (Fig. 3).

Figure 3: Healthy (back) and diseased (front) tomato seedlings infected by Ralstonia solanacearum pathogen. Image copyright: Ville-Petri Friman.
Together, our results suggest that phages can be used as precision tools to engineer the composition and functioning of rhizosphere microbiomes by selectively targeting pathogenic bacteria. Moreover, phage resistance evolution could be advantageous if phage biocontrol efficiency can be increased by choosing phages that select for costly phage resistance adaptations via evolutionary trade-offs (Wang et al. 2017).
References:
Wei, Z., Gu, Y., Friman, V. P., Kowalchuk, G. A., Xu, Y., Shen, Q., & Jousset, A. (2019). Initial soil microbiome composition and functioning predetermine future plant health. Science Advances, 5(9), eaaw0759.
Wang, X., Wei, Z., Li, M., Wang, X., Shan, A., Mei, X., ... & Friman, V. P. (2017). Parasites and competitors suppress bacterial pathogen synergistically due to evolutionary trade‐offs. Evolution, 71(3), 733-746.
Follow the Topic
-
Nature Biotechnology
A monthly journal covering the science and business of biotechnology, with new concepts in technology/methodology of relevance to the biological, biomedical, agricultural and environmental sciences.


Please sign in or register for FREE
If you are a registered user on Research Communities by Springer Nature, please sign in